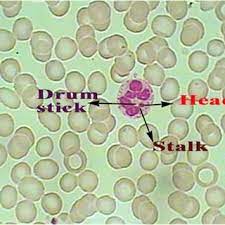
Neutrophil: Drumstick with head connected by a narrow filamentous stalk. | Download Scientific Diagram

- Skeleton as a Forensic Evidence
- Blood as a Forensic Evidence
- Fingerprint as a Forensic Evidence
- DNA as a Forensic Evidence
Introduction
Forensic science is the application of the techniques of science to legal matters, both criminal and civil (Bell et al., 2008). Forensic science includes a number of disciplines and sub-disciplines such as forensic anthropology, forensic engineering, forensic medicine, forensic ecology, forensic pathology, forensic chemistry, etc.
Forensic anthropology is the application of knowledge and techniques of physical anthropology to study questions of medicolegal importance. According to Houck and Siegel, 2010, forensic anthropology is the application of the study of humans to situations of modern legal or public concern. The objective of forensic anthropologists is to assist in the identification of human remains and personal identification including age, sex, ethnicity, stature and unique features, if any.
There are different types of evidences including skeleton, body fluids like blood, fingerprints, etc., that can be found in a crime scene and are used by forensic anthropologist for personal identification.
1. Skeleton as Forensic Evidence
It is easy to identify a skull, complete skeleton, bones as part of a complete skeleton or individual intact bones, but becomes problematic if the bone is fragmented. Because, things such as plastic or pieces of tree may look like bone and thus create confusion. So, unlike readily identifiable human bones, indifferent bones, and especially for fragmented bone, the key question is, is it bone? Next a forensic anthropologist tried to answer a number of questions like, is it human? Are the bones male or female? What was the age at time of death? What is the race? etc. The answers to these questions are very important, because this will lead to the personal identification of the remains and, possibly, to determine the cause and manner of death.
A. Is it bone or not? : The presence of cortex (outer layer cortex) and cancellous (spongy interior part) tissue differentiate bone from other materials.
B. Is it human?: Skull with rounded vault and flat face indicate that it is a human skull. Randomly scattered osteons in cancellous tissue is indicative of human bone. Dentition and some features of the teeth like filings or caps also indicate that they are of human. Precipitin test is also used for identifying as to species.
C. How long since death? : It is very difficult to determine the time since death because number of factors including temperature, soil type, whether preserved in a coffin or not, etc. affect the decomposition rate of a body.
- Presence of flesh and odor are good indicator of recent death.
- Recent bones will have a “greasy” feel.
- Older bones will be lightweight and have a weakened surfaces or ends.
- Severe tooth wear and erosion into the dentin is indicative of ancient remains.
D. What is the race or ancestry? :It is very difficult ascertain race or ancestry from skeletal remains because no pure race exist today. However, forensic anthropologists are routinely called to assess the skeletal remains for clues as to that person’s ancestral affiliation to help investigator for personal identification.
Table 1. Racial characteristics of the Skull
| Trait | Mongoloid | Caucasoid | Negroid |
| Skull length | Long | Short | Long |
| Skull breadth | Broad | Broad | Narrow |
| Skull height | Middle | High | Low |
| Sagittal contour | Arched | Arched | Flat |
| Face breadth | Very wide | Wide | Narrow |
| Face height | High | High | Low |
| Orbital opening | Rounded | Rounded | Rectangular |
| Nasal opening | Narrow | Moderately wide | Wide |
| Nasal bones | wide, flat | narrow, arched | Narrow |
| Lower nasal margin | Sharp | Sharp | Troughed |
| Facial profile | Straight | Straight | Downward slant |
| Palate shape | moderately wide Broad U-shape | moderately wide V-shape | Wide U-shape |
| Shovel-shaped incisors | 90%+ | <5% | <5% |
| General form | large, smooth | Rounded, large | Smooth, elongated |
E. What is the Sex? : Several elements of the skeleton can be used by a physical anthropologist for determination of sex in adults, but the pelvis and skill are the most reliable elements for determination of sex. For example,
i. The skull has many features that vary in the two sexes:-
Table 2. Sexual characteristics of the Skull
| Trait | Male | Female |
| Supraorbital ridge (ridge above the eyes) | Robust | Gracile |
| Occipital protuberance (base of skull) | Robust | Gracile |
| Mastoid processes (bony process behind ear canal) | Long, broad | Short |
| Chin | U-shaped, square | V-shaped |

ii. The pelvis has many features that vary in the two sexes:-
Table 3. Sexual characteristics of the Pelvis
| Trait | Male | Female |
| Symphysis | High, narrow | Low, wide |
| Sub pubic angle | V-shaped | U-shaped, round |
| Obdurate foramen | Large, ovoid | Triangular |
| Sciatic notch | Narrow, deep | Wide, 70–90 degrees |
| Sacroiliac articulation | Large, straight | Small, oblique |
| Ilium | High, vertical | Wide |
| Sacrum | Long, narrow, straight | Short, broad, curved |
| Pelvic inlet | Heart-shaped | Circular, elliptical |
| Acetabulum | Large | Small |

F. What is the Age? : There are no skeletal features that allow a specific age of the specimen, such as 30 years of age. However, age determination can be done with a range, for example, 45 to 47 years, or 60+ years.
i. Estimation of age from sutures of the skull
Closer of suture gives an idea about the approximate age of the specimen. For example, the presence of large fontanels and wide open sutures in skull indicated that it belongs to an infant. Fusion of the sagittal suture is indicative of about 35 years of age. The Spheno-Parietal suture begins to close about thirty years, but is not usually completely closed until about seventy years.
ii. Estimation of age from the ossification in the epiphysis and their fusion with diaphysis
An estimation of age can be possible by analyzing the times of appearance of ossification in the epiphysis and their fusion with diaphysis of bone. For example, appearance of ossification at the capitulum of humerus, distal radius, distal tibia and fibula indicate one year of age in both sexes. At about twenty-one years of age ossification appears at the medial end of Clavicle in both sexes.
Fusion of the epiphyses of greater tubercle of the head of humerus indicates about four years of age in female and about five years of age in male. Fusion of the epiphyses of the distal phalanges of second, third, and fourth toes indicates about fifteen years of age in both sexes.
iii. Estimation of age from pubic symphysis
The morphological changes of the pubic symphysis are considered one of the most reliable estimators of age at death. For example, in post-adolescent and early adult life, the sub-epiphysial symphysial face presents a transversely billowed (wavy) surface with an increasing sharp dorsal margin and a beveled ventral area. In the letter part of the third decade the billowed texture is lost and a typical ovoid symphysial face results. Toward the end of the fifth decade a narrow beaded rim develops on the margins. During the sixth decade erosion of surface and breakdown of ventral margin begin to modify the configuration of the symphysial face.

iv . Estimation of age from teeth : An examination of the state of eruption of the teeth in infants will offer a reliable indication of age in most cases, since the respective periods of eruption of the different teeth are fairly constant.
Approximate period at which the different temporary and permanent teeth appear:-
a. Temporary or deciduous teeth
Table 4. Estimation of age from temporary teeth

Period Teeth
- 7-9 months Upper central incisor
- 6-8 months Lower central incisor
- 9-10 months Lateral incisor
- 18 months Canine
- About 12 month First molar
- About 2 years Second molar
B. Permanent teeth
Table 5. Estimation of age from permanent teeth
Period Teeth
- 7th year Central incisor
- 8th year Lateral incisor
- 11th year Canine
- 9th year First premolar
- 10th year Second premolar
- 6th year First molar
- 12th year Second molar
- 17th -21st year or later Third molar
G. What is the stature? : Living stature is directly related to the length of bone, specially, the long bone of the lower limbs. However, to estimate stature, the only difficulty is that sex and ethnicity must be known to correctly, because the prediction equations are dependent on sex and ethnicity. For example, a White male with a femur length of 55.88 cm. would be estimated to have been between 189 cm and 196 cm tall. This can be done by the following regression equation.s
For white males: Stature = {(2.38 x Humerus length) + 61.41 +/− 3.27}
H. DNA from skeleton as personal identification : DNA profiling can play an important role in personal identification , especially when the bones are very fragmentary and other ways of personal identification is not possible.
I. Facial reconstruction : One of the widely used practices in forensic anthropology for personal identification is facial reconstruction based on the features of the skull. In this process, the soft tissues of a face are reconstructed on a skull to create a likeness of that individual.
Introduction If a skull is accidentally recovered from a garden, forest etc, a positive identification will be needed. This is essential not only for legal purposes but also aids in the family’s in overcoming their grief and bring a sense of closure to them. In such cases, where traditional methods of identification like dental records examination, radiography, DNA analysis etc. cannot be used or have been ineffective due to some problems such as lack of proper information, condition of the remains, cost etc. Forensic facial reconstruction can be used as an important forensic tool which may help in facial recognition of the skull and ultimately lead to positive identification of an individual . Forensic facial reconstruction is a combination of both scientific methods and artistic skill. It can be used to reconstruct the soft tissues onto the skull in order to obtain the image of an individual for his/her recognition and identification . Some reviewers considered that forensic facial reconstruction is a method of facial approximation, i.e. various facial patterns can be established from the same skull. Other researchers on the other hand felt that each skull can only produce one face and this would hence lead to positive identification of an individual, they used the term “Facial Reconstruction”. Forensic facial reconstruction is used in both forensic science and Archaeology. In forensic science, this method is used in the identification of an individual where the conventional\usual methods of identification are unsuccessful. In Archaeology, it is used to identify the faces of the people from the past, bone remains, embalmed bodies, etc . The face of an individual has several different types of exclusive features and thus, is of great importance in identification and recognition of a person. When an unidentified body is found, a facial photograph is clicked. This photograph is sometimes digitally processed so that it becomes suitable for the witness to identify or for the newspaper to publish legal which may ultimately leads to identification of the corpse. The victim’s family, friends/or acquaintance are required to visually identify the victim and the only body part uncovered for identification is the face. Sometimes, a dead body cannot be identified as its face cannot be recognized due to destruction by animals, physical attacks or decay caused by environmental factors. Forensic facial reconstruction is an alternative method in the identification process where there is little or no other evidence available . The reconstruction techniques can be divided into two types: Two dimensional (2D) and three dimensional (3D) techniques . They are carried out and analysed either manually or by using specific software (computerized). The 3D manual methods used in forensic facial reconstruction are the Anatomical (Russian), Anthropometrical (American) and Combination Manchester (British) methods which were developed by Gerasimov, Krogman and Neave respectively . Discussion The first facial reconstruction was done by a German anatomist Wilheim His in 1895. He reconstructed the face of German composer Johann Sebastein Bach . Welcker, a German physiologist and anatomist documented average tissue depth thickness from studying cadavers, he inserted a small surgical blade into various anthropometric landmarks on the face and then measured the depth of penetration. This is called as “Welcker Facial Reconstruction Technique”. Facial reconstruction of Schiller, Kant and Dant was done by Welcker by using the same technique. During the late 1880’s and early 1890’s, Wilheim further modified this technique by inserting a thin sharp needle which had a small piece of rubber on its tip instead of using wider blade. This reduced the amount of tissue distortion and lead to more accurate results. Later in 1946, Wilton Maria Krogmann defined five basic principles to modify the methods of reconstruction of soft tissues of the face i.e. the relation of eyeball to orbit, the shape of nose tip, the ear location, the mouth width and the ear length . With the improvement in 3D technology, rapid, efficient and cost-effective computerized facial reconstruction software was developed. The software imitates the manual method of facial reconstruction. Computerized reconstruction was first studied at London College University in the 1980’s where a cranial reconstruction procedure was carried out by using a laser like scanner and video camera. The data was collected and used to build a library of ‘Living subject’ facial surfaces . Two-dimensional reconstruction: This is used to recreate a face from the skull with the use of soft tissue depth estimates. This method was first developed by Karen Taylor in Austin, Texas during the 1980’s. This method requires an artist and a forensic anthropologist to work together on the facial reconstruction and is based on antemortem photographs and the skull which is to be reconstructed . This method is also used in identification of the deceased from skeletal remains. Now a days, various computer software programs like CARESTM or CARES (Computer Assisted Recovery Enhancement System) and FACES (Forensic Anthropology Computer Enhancement System) etc quickly produce 2D reconstruction which can be edited and manipulated. They work by capturing and digitalizing radiographs, photographs and images of skulls and producing an electronically altered version of the image. These programs speed the reconstruction process and produce more generic images . Three-dimensional manual reconstruction: This method also needs both an artist and a forensic anthropologist. In manual methods, facial reconstruction is done by using clay, plastic or wax directly on the victim’s skull or more often a replica of the skull which has to be identified. This method is similar to two dimensional methods as it also requires the use of tissue depth markers of specified lengths to represent different soft tissue depths. The markers are inserted into small holes on the skull cast at specific strategic points or landmarks. In the computerized method, computer software produces reconstruction by using scanned and stock photographs Methods of Manual 3D Reconstruction Anthropometerical American Method/ Tissue Depth Method: This was developed by Krogman in 1946. Through this method, soft tissue depth data is considered. This method was commonly used for reconstruction by law enforcement agencies . Fine measurements were obtained by the use of needles, X-rays or ultrasound. As facial muscles are recorded in a proper anatomical manner, this method requires highly trained personnel , so this technique is not preferred now a days. Anatomical Russian Method: This method was developed by Gerasimov in 1971. Here soft tissue depth data was not considered but facial muscles were used in anatomical position. In this method, reconstruction was done by shaping muscles, glands and cartilage onto the skull layer by layer. This technique is not commonly used in these days. This method is much slower than the American method and a greater degree of anatomical knowledge is required. Reconstruction of fossilized skulls have been achieved by this method . Combination Manchester Method/ British Method: This method was developed by Neave in 1977 and is the most accepted method for facial reconstruction today. In this technique, both soft tissue thickness and facial muscles are taken into consideration. Once the cranium and mandible are articulated and the skull is mounted on an adjustable stand in the Frankfort Horizontal plane, facial tissue pegs or markers are then added on the skull, either by placing them directly on the skull or by inserting them on previously drilled holes on the cast at 90 degree using a 3mm drill bit . Each peg length represents the mean tissue depth at the anatomical point. The facial tissue depth is determined by the age, gender, build etc. of the individual. The muscles of mastication and facial expression are constructed out of the modeling material and positioned on the basis of their origin and insertion on the skull. The shape and size of various muscles are determined on the basis of the underlying hard tissues. Plaster or prosthetic plastic eye balls of 25mm diameter are placed into the orbits. The prosthetic eye balls are positioned in the orbit in such a way so that a tangent taken from the mid supraorbital margin to the mid infraorbital margins touches the iris. The inner canthus are placed 2mm lateral to the lacrimal crest and the outer canthus are placed 4mm medial to the malar tubercle. When the malar tubercles are absent, the outer canthus is placed 10mm below the line of frontozygomatic suture and 5-7mm from the orbital margin . The maximum width of the nose is determined by the bony nasal aperture at its widest point as three-fifths of the overall width of the soft nose. The profile of the nose and the shape and the size of the alae are determined by the nasal aperture. The maxillary canine and first premolar are placed near the corners of mouth and width of the mouth corresponds to six anterior teeth. The thickness of lips is determined by upper and lower anterior teeth . The length of the ear is predicted by the length of the nose and the ear canal is positioned by using external auditory meatus as the reference point. Muscles of the face are usually modelled on the skull which is to be reconstructed in clay one by one, then a layer of clay is added over the musculature to represent the skin, subcutaneous fats and strips of clay are then rolled, shaped and added over the muscle/fat structure to create the finished face by maintaining the length of the pegs as a guide to the final tissue guides over the face . Photograph showing tissue-pegs attached to the surface of the skull at the anatomical landmarks. Computerized 3D Forensic Facial Reconstruction: With the advancement in 3D technology, a fast, efficient and cost effective computer aided forensic facial reconstruction method was developed. In this method, the operator used 3D computerized models using manual clay model techniques. Some computerized systems used 3D animation software (Free Form Modelling PlusTM; Sensable Technologies, Wilmington MA) to model the face onto the skull while other system used virtual sculpture system with Haptic feedback (Phantom DesktopTM Haptic Device; Sensable Technologies). Haptic feedback system has the ability to feel the surface of the skull during analysis and also provide important skeletal details for facial reconstruction such as muscle attachment strength, position of eye, position of malar tubercle etc. This system though requires both anthropological and computer modelling skills. It decreases practitioner’s subjectivity and skill. This method also creates multiple images of the same face quickly and efficiently . Conclusion Forensic facial reconstruction is a rapid, non-invasive and efficient method where reconstruction can be repeated at any time if required. This technique is not only used for identification of individuals from skeletal remains but is also used for archaeological research purposes. Visual identification by the individual’s family and associates thus becomes easy and more defined. For the classical manual technique, various methods are used but the Combination Manchester Method was found to be the best and most accurate method for the positive identification of an individual. The manual methods on the other hand are labour intensive. Computerized forensic facial reconstruction can also mimic the manual method of facial reconstruction. Computerized remodeling of missing individual is also significantly easier as compared to the manual method and also decreases practitioner training.
3. Blood as Forensic Evidence
In crime of violence body fluids are routine encountered as viral evidence. Blood is the most common form of biological material that is recovered from crime scenes. Along with other evidence, blood stain analysis may be used to place a person at a crime scene, or possibly to completely exclude that person.
A. Is the sample blood? :There are many stains such as rust, paint, wine etc. which look like blood. Thus, chemical tests are essential to confirm whether the sample is blood or not.
i. Presumptive tests : Presumptive tests are generally used at the crime scene and merely confirm that the substance in question is most likely blood. For example,
- Phenolphthalein test: At first a clean cotton swab dip in distilled water and then rubbed on the suspected stain. A drop of phenolphthalein solution is then added to the swab’s tip. A drop of hydrogen peroxide is then added; if the tip turns pink, the test is presumptively positive for blood.
- Luminol test: Luminol (3-aminophthalhydrazide) is sprayed in crime scene which reacts in the presence of haemoglobin, when an oxidizer is applied. The reaction, however, results in a blue-white to yellow-green luminescence (light emitted as a by-product of a chemical reaction) if blood is present.
ii. Confirmatory Tests for Blood
a. Takayama test or hemochromogen test
The commonly used confirmatory test for blood is the Takayama test or hemochromogen test. In this test a small sample of the presumptive stain is placed under a cover slip and heated lightly. Then pyridine under alkaline conditions in the presence of a reducing sugar is added with a pipette in it. If blood is present, salmon-colored crystals will form and can be viewed through a microscope.
B. Is the sample human blood? : There are a number of tests that can be used to identify human blood, for example,
- Immunohematology: Antigen – antibody agglutination test, precipitation test
- Electrophoresis: For identification of red cell enzyme, serum protein
- Molecular marker: Most stable DNA isolation and test for human kind RFLPs
C. What is the Sex? : Presence of drumstick in WBC indicates female sex and its absence indicate male sex.
D. Genetic Markers in Blood : Blood possess a number of genetic markers both in cell and serum including ABO blood group, Rh, MNS, PGM, and HP etc. for personal identification.
E. DNA from blood for personal identification : Once it is confirmed as human blood, DNA can be extracted from WBC for DNA profiling and personal identification (details will be discussed later under the sub-heading of ‘DNA as forensic evidence’).
F. Bloodstain Pattern Analysis : Often found at the scenes of violent crimes, the analysis of bloodstains can provide vital clues as to the occurrence of events. For example, Venus blood will show fine droplets with striking surface right angled star like. Artery blood generally will show oblique pattern due to pressure.

4. Fingerprint as Forensic Evidence
Fingerprints have long been considered as the backbone of forensic identification, even in the age of DNA technology. This is because of the fact that fingerprints are matchless to the individual and thus, assumed that a match between a suspect print and an evaluation print is sufficient to individualize the evidence and link it to a common source.
A. Classification of fingerprints patters : There are four types of pattern namely, Arch, Loop, Whorl and Composite. The arches are either plain arch or tented arch. Loops are further subdivided in two types depending on their openings as ulnar loop and radial loop. Whorls are also further subdivided into plain whorl, central pocket loop, double loop, and accidental.

B. Minutiae : Along with fingerprint pattern, the ridge of each fingerprints also contain unique features which allow them for personal identifications. These ridge characteristics are collectively known as minutiae. This includes the patterns of the pores on fingerprints, bifurcations, island, short ridge, termination, enclosure, etc.

C. Types of fingerprint commonly found in crime scenes : Three types of fingerprints are commonly observed in crime scenes, namely,
- Visible – it is clearly visible, does not require processing and can be found on substance such as paint or blood.
- Plastic – it is also clearly visible, does not require processing and can be found on soft surface, such as tar, putty.
- Latent – it requires treatment to be visualized and can be found for example, on human skin.
D. Latent fingerprints : A latent fingerprints is one left on an objects surface when it is touched. The oldest and still most common method to make visible latent fingerprint is to use fingerprint powder of contrasting colour by a soft fiberglass brush to create contrast between the ridge pattern and the background. Once a latent print becomes visible, it is photographed.



A number of chemical methods are also available for the visualization of latent prints, for example,
- Ninhydrin: Ninhydrin is used to develop latent prints (purple colour) on porous surfaces like paper by reacting with amino acids in latent print residue.
- Iodine: Fumes from iodine crystals develop latent prints on surfaces that are impractical for traditional dusting or have residue such as grease. The print developed are visible only for few hours and then become fade, so it should be photographed immediately once observable.
E. Collection of fingerprint from a crime scene : Fingerprints that are clearly visible can be photographed and the print can be used for comparison. However, for latent fingerprint photograph can be taken only after it become visible by physical or chemical treatment. Sometimes it is possible to lift the latent fingerprint. This can be done by placing a lifting tape on the fingerprint. The lifting tape is then placed on a latent lift card to preserve the print.
F. Comparison of fingerprints for personal identification : The comparison of fingerprints collected from the suspect and from the crime scene for identification is not only made by comparing the patterns or by merely the presence or absence of minutiae, but is done by comparing the presence, kind, number and, especially, the arrangement of the pattern and minutiae characteristics that create a unique pattern
Now days this comparison can be done by automated fingerprint identification systems (AFIS). AFIS is a computer programming which digitized the images of a fingerprint and then encode the details of the minutiae for searching in the database. This system does not identify a person uniquely but rather provide a list of potential matches for the fingerprint examiner to evaluate and make the final determination.
5. DNA as Forensic Evidence
The development and application of human genetics has reformed forensic anthropology in the last two decades. Now a day’s DNA profile makes it possible to associate a DNA sample to a specific person with a high degree of confidence and thus providing a new, powerful identification tool that supplements fingerprints and other methods of identification to the forensic investigation. There are two types of DNA, namely the nuclear DNA (located in the nucleus) and mtDNA (located in the mitochondria). However, both are used for DNA profiling in personal identification.
A. What are the sources of DNA? : DNA samples can be obtained from a number of biological materials including saliva, tissue, blood, hair follicles, semen and bone from a scene of crime.

B. Nuclear DNA : The humans nuclear DNA contains approximately 3.2 billion base pairs and organized into 23 chromosomes. A large portion of this DNA is similar and is required for the protein synthesis. However, there are segments of DNA that vary from person to person and are called hyper variable regions. These regions are commonly used as markers for personal identification. There are several techniques that make DNA typing possible for forensic identification like restriction fragment length polymorphism (RFLP).
i. Restriction fragment length polymorphism (RFLP).
In RFLP analysis a restriction enzyme is used to cut the DNA sample into a number of pieces of variable size. The number and the size of the DNA fragment depend on the variation in the number of times a sequence of base pairs in DNA is repeated. From a forensic anthropological viewpoint, these fragments are extremely polymorphic since the number of repeat sequence varies from person to person. Because the polymorphism comes from the number of repeats, this kind of DNA typing is categorized as VNTR (variable number of tandem repeat). These are length polymorphisms with a core sequence are between 10 and 100 base pairs in length and in one person, this sequence may be repeated fifty times on a given chromosome, while in another person it may repeat ten times. In forensic science, four to six of these highly polymorphic VNTR loci are analyzed, and the results are used to generate DNA profiles for comparison and personal identification.
a. Visualization of VNTRs
The technique by which these VNTRs can be identified is called Southern blotting electrophoresis. In order to visualized the VNTRs, the DNA fragments are loaded into a well at the base of a slab of electrophoresis gel. An electrical current is then applied, which separates the VNTRs based on length and charge of DNA fragment. After that the DNA fragments are stained with radioactive single-strand DNA sequences for visualization and identification.

VNTR alleles
b. Polymerase chain reaction (PCR)
RFLP gives good result when there is large amount of high quality DNA. But, the DNA sample come from a crime scene may not be large in amount and more frequently they are too fragmented to be useful. In this situation PCR technique is used primarily to increase the amount of DNA by amplification. PCR is based on the natural process of DNA replication. PCR uses DNA polymerase to rapidly replicate a specific DNA sequence millions of times.

ii. Short tandem repeats (STRs)
STRs are currently the most commonly analyzed genetic polymorphism in forensic genetics. There are thousands of STRs that can potentially be used for forensic analysis. STR loci are spread throughout the genome including both Autosome and sex chromosomes. STRs have a core unit of between 2 and 6 base pairs and the repeats typically range from 50 to 300 base pairs. STRs have greater advantages over VNTRs, which make STRs more attractive for forensic comparison purposes. For example, STR markers have greater variability in a population, thus giving rise to high degrees of association of evidence with a suspect. There are many STRs to choose from for forensic purposes. Moreover, STRs are much less sensitive to degradation of the DNA due their smaller repeat size. Similar to that of VNTRs, STRs are also identified by electrophoresis and the results are then used to generate DNA profiles for comparison and personal identification.
C. Identification of Sex from DNA : There are two approaches to sex identification from a DNA sample.
- Amelogenin: Presence of one electrophoresis band for Amelogenin locus indicate female sex and presence of two electrophoresis band for Amelogenin locus indicate male sex.
- Y-STRs: The presence of Y-STRs, a sex-specific DNA marker indicates male sex and its absence indicates female sex.
D. Mitochondrial DNA (mtDNA) : MtDNA located in mitochondria and inherited maternally. The human mtDNA is a circular molecule and consisting of 16,569 nucleotides. There are a number of situations where mtDNA becomes a valuable genetic marker, for example, it is very helpful when the amount of cellular material available for analysis is very small or if the source does not contain nucleated cells. Moreover, mtDNA is also advantageous for the study of highly degraded human remains where standard STR typing is not possible. Due to its maternal inheritance, mtDNA is very useful for personal identification of missing person or person in mass disasters, especially when there are no direct relatives to use as a reference sample, because, all maternal relatives share the same type of mtDNA. Analysis of mtDNA is generally performed by comparing the sequences of its hyper-variable regions.
![Mitochondrial DNA in human identification: a review [PeerJ]](https://dfzljdn9uc3pi.cloudfront.net/2019/7314/1/fig-1-2x.jpg)
E. Interpretation of DNA profile : Once it has been established that two DNA profiles are the same, the significance of the match has to be estimated. This significance of the match or probability is calculated by the frequencies of each allele using population data base and indicates the probability of a chance occurrence of a given DNA profile within a chosen population. Thus, in order to reduce the chance occurrence of similar DNA profile, forensic experts are commonly use multi-locus genotype using large number of STR loci for identification. Because, this multi-locus genotype becomes so rare that it is improbable that two people in the world would have the same exact type. This helps the forensic experts to conclude in DNA profile cases that the match of the DNA type from the evidence and the suspect can be used for identification, except in the case of identical twins.